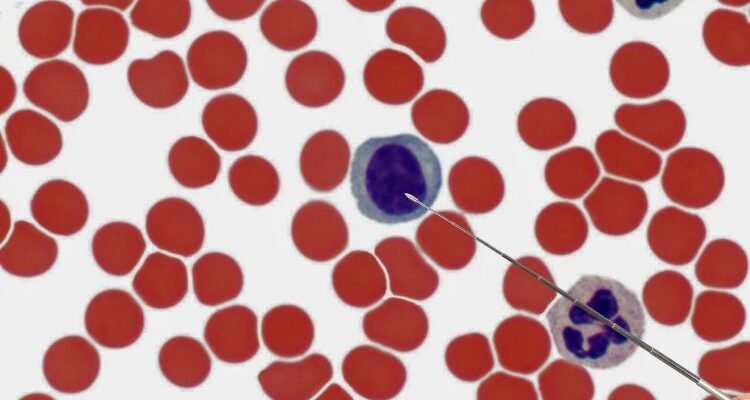
Моноцити: роль, функції та значення в імунній системі людини

LIFE
Що таке пансіон? Пансіон – це особливий рід житла, де ви отримуєте не лише притулок над головою, але й харчування. Досить приємно, коли можна відійти від
Що таке моноцити? Моноцити — величенькі білі кров’яні клітини, які займають приблизно 8-11% всіх лейкоцитів у нашій крові. Важко не помітити: “
Освіта: шлях до знань, саморозвитку та кращого життя Що таке освіта? Це щось більше, ніж просто набір знань та навичок. Освіта — це ваша карта у світ
Орієнтування на місцевості: знайдіть свій шлях у будь-яких умовах Орієнтування на місцевості — що ж це таке? Це здатність, яка дає можливість розуміти
Що таке пауерліфтинг? Пауерліфтинг — вид спорту, де атлети демонструють свою силу в трьох основних вправах: присідання зі штангою, жим лежачи та тяга.
Що таке патрон Флобера? Ну що ж, панове аматори стрільби та колекціонери незвичайних штучок, давайте поговоримо про патрон Флобера. Оцей маленький, але
“` Що таке Парфенон? Парфенон ️ — це храм, розташований на вершині Акрополя в Афінах, Греція. Він вважається одним із найважливіших зразків давньогрецької
Парсуна: вікно в минуле, що таке це мистецтво? Парсуна… Слово, яке наче пихає нас у світ старовинного живопису, сповненого історії, культури та загадки.
Що таке парні і непарні числа? Чи думали ви коли-небудь про числа так глибоко, щоб побачити їхнє внутрішнє розділення на парні та непарні?
Що таке паротит: відома “свинка” Паротит, відомий у народі як свинка, — це загадкове гостре інфекційне захворювання, яке має неприємний вміст